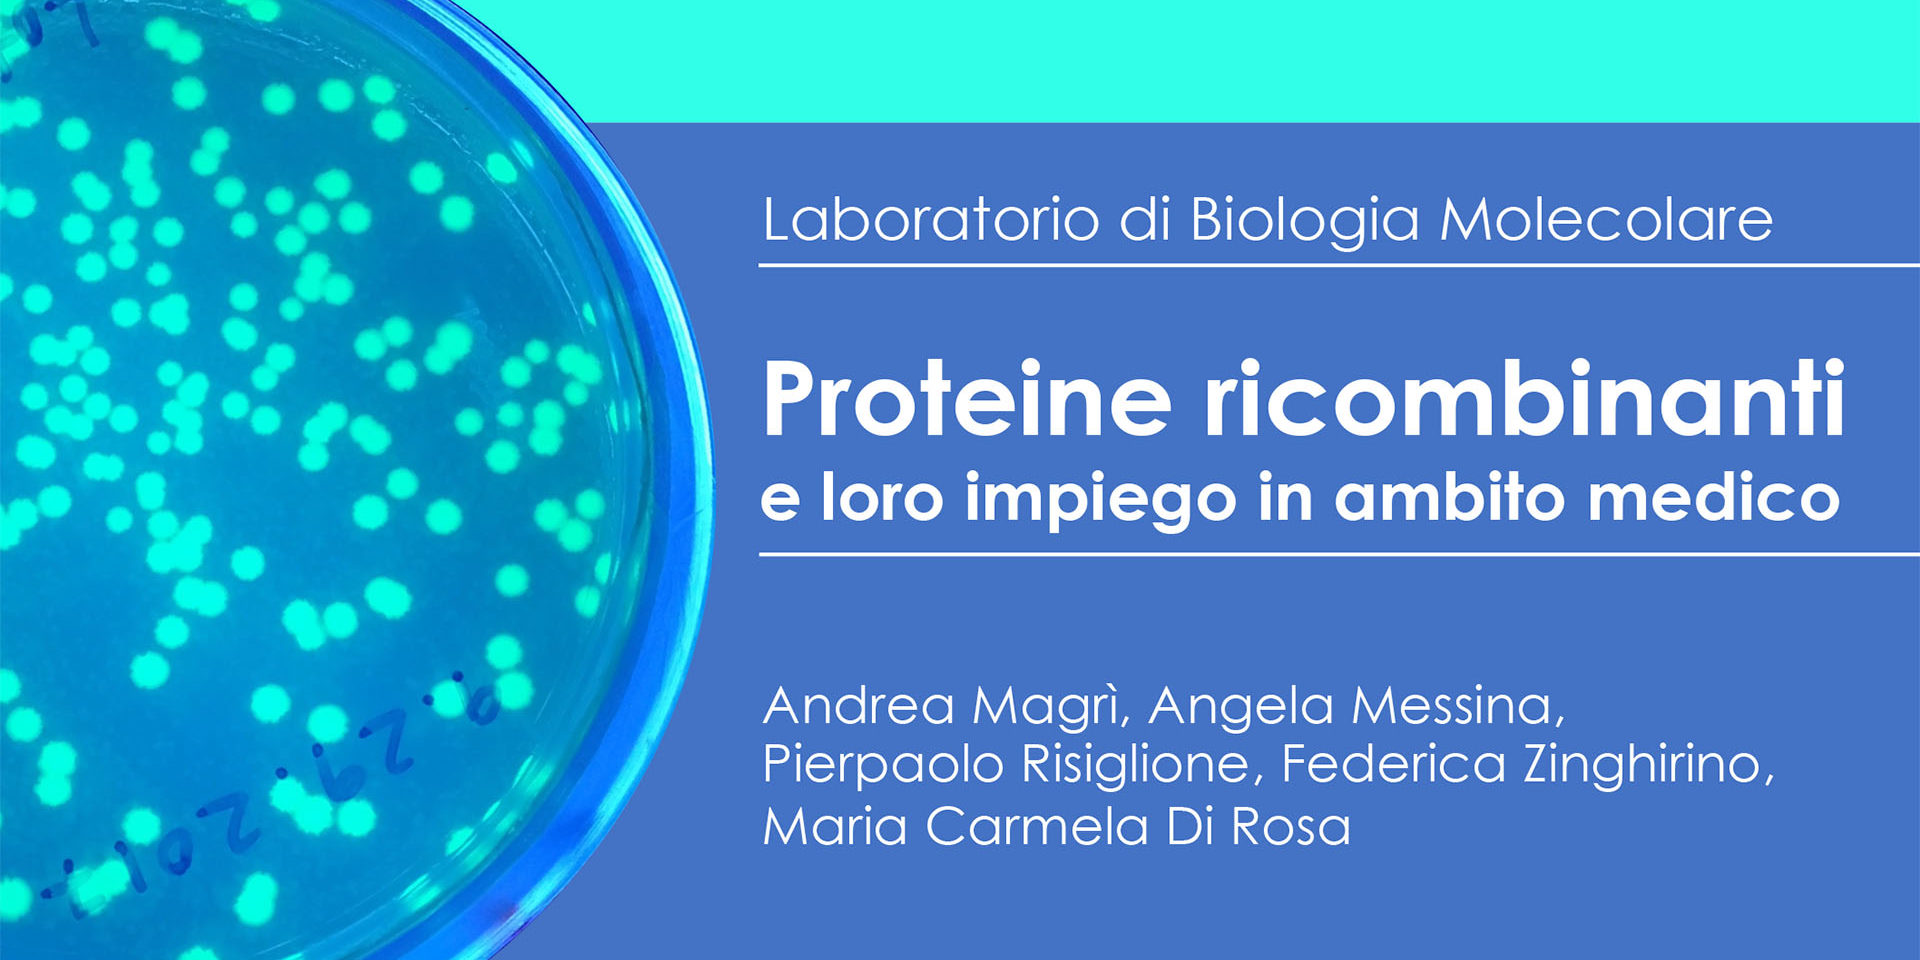

Produzione di proteine ricombinanti e loro impiego nel settore medico
Aggiungi Nuovo DSBGA - Unict, Università di Catania
1475 1475 people viewed this event.
In questo webinar scopriremo come le proteine vengono prodotte in laboratorio, utilizzandone una davvero speciale: la green fluorescent protein, una proteina fluorescente di colore verde brillante! Scopriremo anche il loro impiego nell’ambito medico, e quanto la biologia molecolare sia importante per la salute di tutti noi.